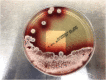

Localized Talaromyces marneffei infection presenting as a tonsillar mass mimicking malignancy
- PMID: 32489876
- PMCID: PMC7256294
- DOI: 10.1016/j.idcr.2020.e00824
Localized Talaromyces marneffei infection presenting as a tonsillar mass mimicking malignancy
Abstract
Talaromyces marneffei is an opportunistic fungal infection seen in immunocompromised patients including those with HIV/AIDS. It is usually seen in patients who live in or are from tropical Asia. In HIV patients, oropharyngeal and laryngeal lesions are usually part of disseminated infection. We describe a case of 63-year-old Vietnamese male with history of HIV/AIDS who presented with localized T. marneffei tonsillar infection without disseminated disease. Imaging studies showed a right tonsillar mass with right cervical lymphadenopathy which was initially thought to be malignancy. The patient underwent biopsy of the mass and histology showed noncaseating granulomas on hematoxylin and eosin stain as well as yeast on Grocott methenamine silver stain. Fungal culture of the biopsy specimen grew suede-like grayish-white colonies with diffuse underlying deep red color pigment which was identified as Talaromyces marneffei. The patient was treated with intravenous liposomal amphotericin B and achieved resolution of symptoms and tonsillar mass. In HIV/AIDS patients who are either from endemic regions or with history of travel to endemic areas particularly Southeast Asia and China, T. marneffei infection should be considered in differential diagnoses of a tonsillar mass.
Keywords: HIV; Opportunistic infection; Oral lesion; Talaromyces marneffei; Tonsillar mass.
© 2020 The Author(s).
Conflict of interest statement
The authors declare that there are no conflicts of interest.
Figures

References
Publication types
LinkOut - more resources
Full Text Sources